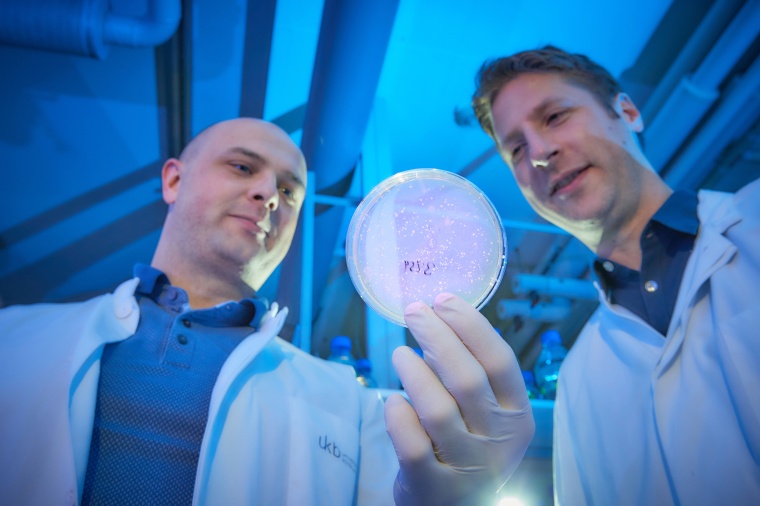
Mit Zellkultur im Labor: Dr. Paul-Albert König (l.) von der Core Facility...

Vielversprechende Antikörper gegen SARS-CoV-2
Ein internationales Forscherteam unter Federführung der Universität Bonn hat neuartige Antikörper-Fragmente gegen das SARS-Coronavirus-2 gefunden und weiterentwickelt.
Diese „Nanobodies“ sind viel kleiner als klassische Antikörper. Sie dringen daher besser ins Gewebe ein und lassen sich leichter in größeren Mengen herstellen. Die Wissenschaftler am Universitätsklinikum Bonn haben die Nanobodies zudem zu potenziell besonders wirksamen Molekülen kombiniert, die gleichzeitig verschiedene Angriffspunkte des Virus attackieren. Der Ansatz könnte verhindern, dass sich der Erreger durch Mutationen dem Wirkstoff entzieht.
Antikörper sind eine wichtige Waffe des Immunsystems zur Abwehr von Infektionen. Sie heften sich an Oberflächen-Strukturen eines Bakteriums oder Virus und verhindern so seine Vermehrung. Eine Strategie im Kampf gegen Krankheiten ist es daher, in großen Mengen wirksame Antikörper herzustellen und den Erkrankten zu spritzen. Der scheidende US-Präsident Donald Trump verdankt dieser Methode möglicherweise seine schnelle Genesung. Die Antikörper, mit denen er behandelt wurde, haben allerdings eine komplexe Struktur, gelangen nicht sehr tief ins Gewebe und können möglicherweise ungewollte Komplikationen hervorrufen. Antikörper zu produzieren, ist zudem schwierig und zeitaufwändig. Für den breitflächigen Einsatz taugen sie deshalb wohl nicht.
Massenproduktion in Hefen oder Bakterien
„Wir setzen dagegen auf eine andere Gruppe von Molekülen, die Nanobodies“, erklärt Dr. Florian Schmidt, der am Institut für Angeborene Immunität der Universität Bonn eine Emmy-Noether-Gruppe zu diesem vielversprechenden neuen Forschungsgebiet leitet. „Dabei handelt es sich um Antikörper-Fragmente, die so simpel aufgebaut sind, dass man sie von Bakterien oder Hefen produzieren lassen kann, was mit geringeren Kosten verbunden ist.“
Allerdings bildet das Immunsystem fast unendlich viele verschiedene Antikörper, und sie alle erkennen unterschiedliche Zielstrukturen. Nur ganz wenige von ihnen sind also z.B. dazu in der Lage, das SARS-Coronavirus-2 außer Gefecht zu setzen. Diese Antikörper zu finden, ähnelt der Suche nach einem einzelnen Sandkorn an Deutschlands Ostsee-Küste. „Wir haben dazu zunächst ein Oberflächenprotein des Coronavirus in ein Alpaka und ein Lama injiziert“, erläutert Schmidt. „Ihr Immunsystem produziert dann vor allem solche Antikörper, die sich gegen dieses Virus richten. Lamas und Alpakas bieten zudem den Vorteil, dass sie neben komplexen normalen Antikörpern auch eine einfachere Variante herstellen, die als Basis für Nanobodies dienen kann.“
Einige Wochen danach entnahmen die Wissenschaftler den Tieren eine Blutprobe. Daraus gewannen sie die genetische Information aller Antikörper, die diese gerade produzierten. Diese „Bibliothek“ enthielt immer noch Millionen verschiedene Baupläne. Mit einem aufwändigen Verfahren sortierten sie diejenigen davon heraus, die eine wichtige Struktur auf der Oberfläche des Corona-Virus erkennen, das Spike-Protein. „Insgesamt erhielten wir so Dutzende Nanobodies, die wir dann weiter untersuchten“, erklärt Dr. Paul-Albert König, Leiter der Core Facility Nanobodies an der Medizinischen Fakultät der Universität Bonn und Erstautor der Studie.
Vier von mehreren Millionen
Vier Moleküle erwiesen sich in Zellkulturen tatsächlich als effektiv gegen den Erreger. „Durch Röntgenstruktur- und Elektronenmikroskopie-Analysen konnten wir zudem zeigen, auf welche Weise sie mit dem Spike-Protein des Virus interagieren“, erklärt König. Diese Arbeiten erfolgten in den Arbeitsgruppen um Martin Hällberg (Karolinska Institutet, Schweden) und Nicholas Wu sowie Ian Wilson (Scripps Research Institute, USA). Das Spike-Protein ist entscheidend für die Infektion: Es wirkt wie eine Art Klettband, mit dem sich der Erreger an die angegriffene Zelle heftet. Danach ändert das Klettband aber seine Struktur: Es wirft den Bestandteil ab, der für die Anheftung wichtig ist, und sorgt dafür, dass die Hülle des Virus mit der Zelle fusioniert. „Auch die Nanobodies scheinen diese Strukturänderung auszulösen, bevor das Virus auf seine Zielzelle trifft – ein unerwarteter und neuartiger Wirkmechanismus“, sagt König. „Die Änderung ist vermutlich irreversibel; das Virus kann also nicht mehr an seine Zielzellen binden und sie infizieren.“
Darüber hinaus nutzen die Wissenschaftler einen weiteren großen Vorteil von Nanobodies gegenüber Antikörpern: Durch ihren einfachen Aufbau lassen sie sich leicht zu Molekülen kombinieren, die mehrere hundert Mal effektiver sein können. „Wir haben zwei Nanobodies fusioniert, die sich gegen unterschiedliche Teile des Spike-Proteins richten“, erklärt König. „Diese Variante war in Zellkulturen hochwirksam. Zudem konnten wir nachweisen, dass so die Wahrscheinlichkeit drastisch sinkt, dass das Virus durch eine Mutation resistent gegen den Wirkstoff wird.“ Mittelfristig könnten sich die Moleküle zu einer neuen vielversprechenden Therapieoption entwickeln, sind die Forscher überzeugt.
Das Unternehmen Dioscure Therapeutics, eine Ausgründung der Universität Bonn, soll die Nanobodies in klinischen Studien testen. Der Erfolg des Projektes basiere vor allem auf der exzellenten Zusammenarbeit der beteiligten Arbeitsgruppen an der Universität sowie mit den nationalen und internationalen Kooperationspartnern, betont Florian Schmidt, der auch Mitglied im Exzellenzcluster Immunosensation2 der Universität Bonn ist.















